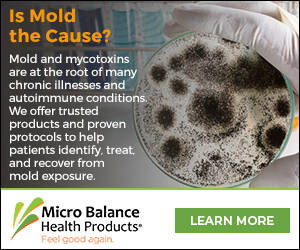

Schimmel testen
De rapporten van giftigeschimmels.nl zijn specifiek gericht op het leveren van technisch en analytisch bewijs voor schimmelproblematiek. Ze worden vaak ingezet bij geschillen met verhuurders, verzekeraars of bij de aankoop van een woning.
Wat staat er in de rapporten?
- Data uit de InstaScope: De rapporten bevatten directe resultaten van luchtmetingen die ter plaatse zijn uitgevoerd. Hiermee wordt de concentratie en het type schimmelsporen in verschillende ruimtes in kaart gebracht.
- Laboratoriumanalyse: Indien nodig worden monsters naar internationale laboratoria gestuurd voor gedetailleerd onderzoek naar mycotoxines (giftige stoffen).
- Saneringsadvies: Het rapport beschrijft welke stappen nodig zijn voor een veilige verwijdering, inclusief protocollen om kruisbesmetting te voorkomen.
- Briefrapportage: Na een inspectie ontvang je een schriftelijk document dat de bevindingen samenvat.Giftige Schimmels +3
Juridische waarde
De rapporten kunnen dienen als deskundigenbewijs in een juridische procedure.Arslan & Arslan Advocaten
- Huurgeschillen: Je kunt een dergelijk rapport gebruiken bij de Huurcommissie of de kantonrechter om aan te tonen dat er sprake is van een ernstig gebrek aan de woning.
- Bewijskracht: Omdat de metingen objectief zijn (gebaseerd op technologie en labonderzoek), hebben ze een hogere bewijswaarde dan een eigen waarneming. De uiteindelijke waarde wordt echter altijd door de rechter of commissie gewogen in combinatie met andere feiten.Bewijs in strafzaken +3
Belangrijk om te weten
Hoewel de rapporten technisch sterk zijn, is het bij gezondheidsklachten altijd raadzaam om ook een medisch rapport van een arts of de GGD toe te voegen. Dit koppelt de aanwezige schimmels direct aan jouw fysieke klachten.Rijksinstituut voor Volksgezondheid en Milieu | RIVM +1

ChatGPT zei:
Je kunt hier gerust een foto uploaden 📸, dan kan ik je helpen bij het herkennen van de paddenstoelen/schimmels.
Wel belangrijk om te weten:
-
Ik kan geen 100% veilige determinatie garanderen. Zelfs experts met jarenlange ervaring kijken vaak in detail (bijv. microscopie, geur, sporenprint).
-
Veel giftige soorten lijken sterk op eetbare soorten. Voor consumptie moet je dus altijd een mycoloog of officiële instantie raadplegen.
-
Ik kan je wel vertellen welke soorten de schimmels lijken te zijn, of ze bekend staan als giftig/verdacht, en waar je op moet letten.
👉 Wil je de foto hier uploaden?
Je zei:
ChatGPT zei:
Dank voor je upload 🙏
Ik zie dat dit een petrischaal is waarin verschillende soorten schimmels en bacteriekolonies groeien. Er zijn duidelijk meerdere kleuren en structuren aanwezig (groen-blauw, wit pluizig, gladde crème-kleurige kolonies, en zelfs wat donkerdere vlekken).
⚠️ Belangrijk:
-
Dit is een mengsel van verschillende micro-organismen. Alleen met het blote oog (macroscopisch) is het onmogelijk om exact te bepalen welke soorten dit zijn. Hiervoor zijn microscopie, kweek op selectieve media, en eventueel DNA-analyse nodig.
-
Sommige kolonies lijken op Penicillium- of Aspergillus-soorten (groen-blauwe kolonies), die vaak in huisstof en op voedsel voorkomen. Deze kunnen mycotoxinen produceren → potentieel schadelijk om in te ademen.
-
De gladde, bolvormige crème-achtige kolonies zouden bacteriën of gisten kunnen zijn.
-
De pluizige witte/groene kolonies zijn typisch voor schimmels die sporen vormen en makkelijk verspreiden.
👉 Veiligheidsadvies:
-
Niet openen! De petrischaal bevat waarschijnlijk sporen van soorten die bij inademing schadelijk kunnen zijn.
-
Bewaar hem in een goed afgesloten zak of container, of lever hem in bij een lab/onderwijsinstelling die dit kan afvoeren.
-
Raak de binnenkant absoluut niet aan.
-
Gooi het niet zomaar bij het huisafval zonder het eerst veilig te verpakken (dubbel plastic zakje, liefst met desinfectiemiddel).
Wil je dat ik een lijst maak van de meest waarschijnlijke schimmelgeslachten die er in zo’n schaal kunnen voorkomen (met hun mogelijke risico’s)?
Je zei:
ChatGPT zei:
Hier is een overzicht van veel voorkomende schimmels en gisten die je in een petrischaal als deze kunt tegenkomen, met hun mogelijke risico’s.
📋 Mogelijke schimmel- en gistgeslachten in jouw schaal
1. Penicillium
-
Uiterlijk: Groen-blauwe, poederige kolonies.
-
Waar vaak te vinden: Op brood, fruit, binnenlucht, vochtige muren.
-
Risico’s: Sommige soorten produceren mycotoxinen (zoals ochratoxine). Bij gevoelige mensen → luchtwegklachten, allergieën, astma.
2. Aspergillus
-
Uiterlijk: Groene, zwarte of geelachtige kolonies met poederige sporen.
-
Waar vaak te vinden: Huisstof, lucht, compost, noten, granen.
-
Risico’s:
-
Aspergillus fumigatus: kan bij inademing longinfecties veroorzaken (aspergillose).
-
Aspergillus flavus: produceert aflatoxinen → zeer giftige stoffen, kankerverwekkend.
-
3. Cladosporium
-
Uiterlijk: Donker olijfgroen tot zwart, fluweelachtig.
-
Waar vaak te vinden: Hout, textiel, muren.
-
Risico’s: Over het algemeen niet extreem gevaarlijk, maar kan allergieën en astma verergeren.
4. Fusarium
-
Uiterlijk: Witte tot roze kolonies.
-
Waar vaak te vinden: Op planten, granen, aarde.
-
Risico’s: Produceert trichothecenen en fumonisinen → giftige mycotoxinen.
5. Mucor / Rhizopus (broodschimmels)
-
Uiterlijk: Snelle groei, witte pluizen die later grijs/zwart worden.
-
Waar vaak te vinden: Brood, groente, aarde.
-
Risico’s: Bij gezonde mensen meestal onschuldig, maar kan bij immuunzwakke personen ernstige infecties veroorzaken (mucormycose).
6. Candida (gist)
-
Uiterlijk: Gladde, ronde, crème-kleurige kolonies.
-
Waar vaak te vinden: Normaal in menselijk microbioom (mond, huid, darmen), ook in omgevingen met suiker.
-
Risico’s: Kan bij verstoorde balans overgroeien → schimmelinfecties (candida-infecties).
⚠️ Samenvattend
-
Er groeien meerdere soorten tegelijk in jouw schaal.
-
Penicillium en Aspergillus zijn het meest waarschijnlijk bij de groen/blauwe kolonies.
-
De witte pluizige kolonies kunnen Mucor of Rhizopus zijn.
-
De gladde crème-kolonies kunnen gisten zoals Candida zijn.
-
Alle genoemde groepen bevatten soorten die irriterend, giftig of zelfs gevaarlijk kunnen zijn.
👉 Tip: Als dit een experiment is geweest, raad ik aan de schaal niet verder open te maken en hem veilig af te voeren.
Wil je dat ik ook een praktische handleiding maak voor veilig opruimen en weggooien van de schaal (zonder speciaal labmateriaal)?
Schimmel testen
Beschimmelde schoenzool met snel test

Volgens het Amerikaanse schimmelprotocol (zoals gehanteerd door instanties zoals de EPA – Environmental Protection Agency – en richtlijnen van CDC en IICRC), moet een beschimmelde schoen meestal worden weggegooid vanwege de volgende redenen:
🦠 1. Porositeit van materialen
Schoenen bestaan vaak uit poreuze materialen zoals leer, textiel en schuimrubber. Schimmelsporen dringen diep door in deze materialen, waardoor:
-
Reiniging niet effectief is.
-
Sporen blijven achter ondanks oppervlaktereiniging.
-
Gezondheidsrisico’s blijven bestaan.
⚠️ 2. Gezondheidsrisico’s
Volgens het Amerikaanse protocol kunnen schimmels zoals Stachybotrys, Aspergillus of Penicillium:
-
Allergieën, ademhalingsproblemen of mycotoxiciteit veroorzaken.
-
Opnieuw verspreid worden via de schoen, vooral in huis of bij gevoelige personen (zoals kinderen of mensen met astma).
🧽 3. Schoonmaken is vaak niet effectief
De EPA en IICRC S520 (de standaard voor professionele schimmelbehandeling) stellen:
-
Poreuze items die zichtbaar beschimmeld zijn moeten meestal worden verwijderd en afgevoerd, tenzij ze van hoge waarde zijn en professioneel kunnen worden gerestaureerd.
🧼 4. Kruisbesmetting voorkomen
Zelfs als je denkt dat je de schimmel verwijderd hebt, blijven sporen aanwezig. Deze kunnen:
-
Andere kledingstukken besmetten.
-
Via je voeten of handen verspreid worden naar andere ruimtes.
✂️ 5. Kosten-batenafweging
Professionele reiniging van een schoen is vaak:
-
Duurder dan het vervangen ervan.
-
Niet gegarandeerd effectief.
👉 Conclusie volgens het Amerikaanse schimmelprotocol:
Beschimmelde schoenen = weggooien, tenzij ze extreem waardevol zijn en professioneel gerestaureerd kunnen worden.
Gezondheid en veiligheid gaan voor.



Reactie plaatsen
Reacties